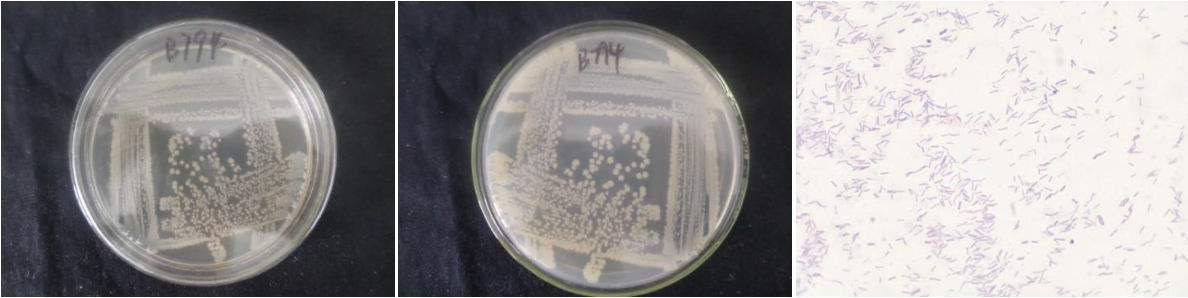

Loading...
| StrainNO | B794 |
| Classification | Bacillus |
| 16s rDNA sequence | CGAACTGGCGCGTGCCTATACATGCAAGTCGAGCGGAGTTTTGAAAAGCTTGCTTTTCAAAACTTAGCGGCGGACGGGTGAGTA ACACGTGGGCAACCTGCCCTTGAGACGGGGATAACTCCGGGAAACCGGAGCTAATACCGGATAACACATATCTTCGCATGAGGA TATGTTAGAAGGTGGCTTTTAGCTACCACTCAAGGATGGGCCCGCGGCGCATTAGCTAGTTGGTGAGGTAACGGCTCACCAAGG CGACGATGCGTAGCCGACCTGAGAGGGTGATCGGCCACACTGGGACTGAGACACGGCCCAGACTCCTACGGGAGGCAGCAGTAG GGAATCTTCCGCAATGGACGAAAGTCTGACGGAGCAACGCCGCGTGAGTGATGAAGGTTTTCGGATCGTAAAGCTCTGTTGTTA GGGAAGAACAAGTACCTGTTAAATAAGCAGGTACCTTGACGGTACCTAACCAGAAAGCCACGGCTAACTACGTGCCAGCAGCCG CGGTAATACGTAGGTGGCAAGCGTTGTCCGGAATTATTGGGCGTAAAGCGCGCGCAGGCGGTTCCTTAAGTCTGATGTGAAAGC CCACGGCTCAACCGTGGAGGGTCATTGGAAACTGGGGAACTTGAGTGCAGAAGAGGAGAGCGGAATTCCACGTGTAGCGGTGAA ATGCGTAGAGATGTGGAGGAACACCAGTGGCGAAGGCGGCTCTCTGGTCTGTAACTGACGCTGAGGCGCGAAAGCGTGGGGAGC GAACAGGATTAGATACCCTGGTAGTCCACGCCGTAAACGATGAGTGCTAAGTGTTAGAGGGTTTCCGCCCTTTAGTGCTGCAGC AAACGCATTAAGCACTCCGCCTGGGGAGTACGGTCGCAAGACTGAAACTCAAAGGAATTGACGGGGA |
| Strain Morphology Photos | |
| Morphological Description | Colony round;offwhite;edge serrated;edge bumps;Many wrinkles;slippy;sticky;waxy;strain:Rod;having spore;terminal spore |